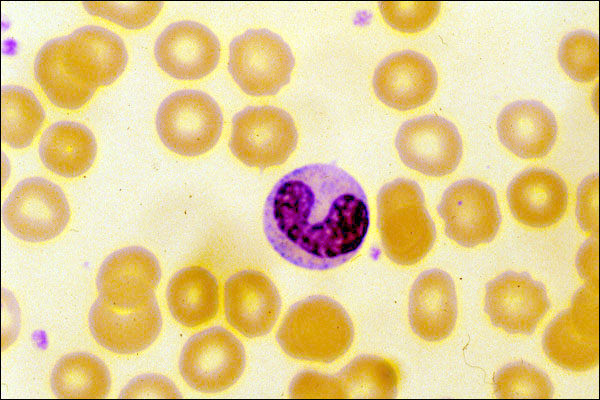

Left shift
Click picture to enlarge. Close window to return
This is a photograph of an immature, "band" neutrophil. Note that its nucleus is sausage-shaped, rather than lobated, like it would be in a mature neutrophil. Were there to be a large number of immature neutrophils in the circulation, the leukogram would be characterized as having a "left shift". When the absolute number of neutrophils in the circulating blood is reduced in conjunction with a left shift, the left shift is said to be "degenerative" (see these terms in your key words sec